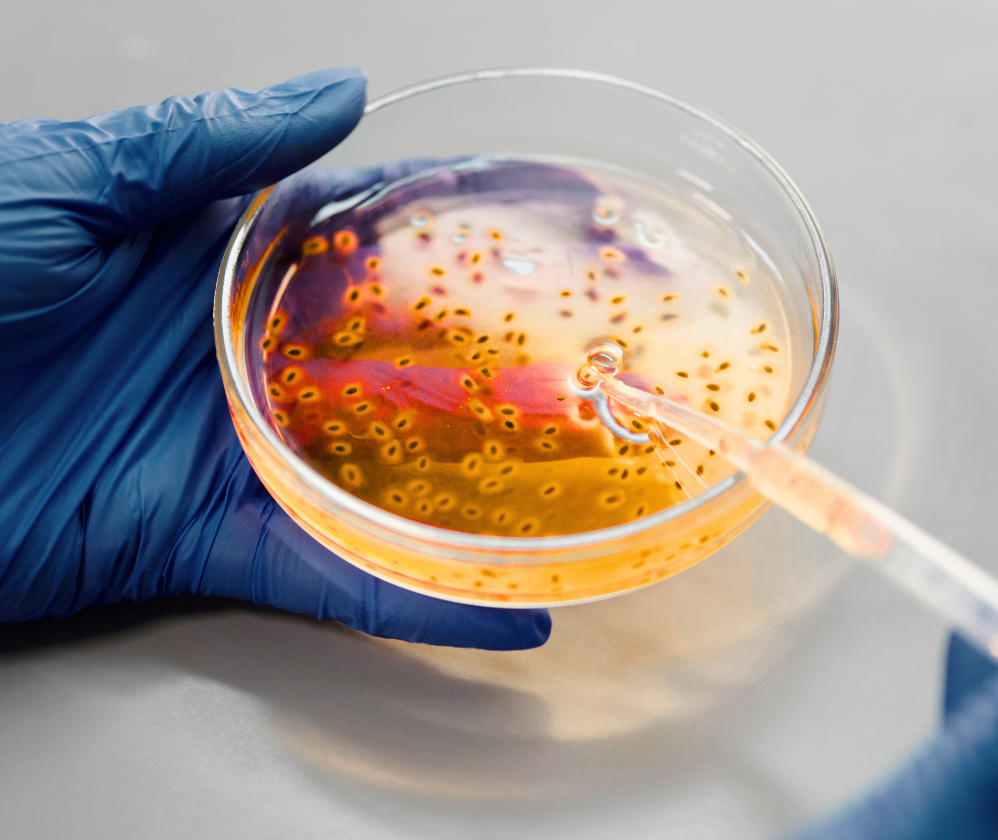
service-overview-microbio

Unsere Prüf- und Beratungskompetenz
Wir schützen Ihre Produkte in jeder Entwicklungsstufe.
Mikrobiologische Qualitätsprüfung
Wir gewährleisten die Einhaltung internationaler Sicherheitsvorschriften; stellen potentielle mikrobielle Verunreinigungen fest und überprüfen die Wirksamkeit des Konservierungssystems.
Gesamtkeimzahlbestimmung
Um Produkthygiene und mikrobiologische Qualität zu überwachen ist die Überwachung einer potentiellen Belastung durch Hefen, Schimmelpilze und aerobe Mikroorganismen in Rohstoffen und marktfähigen Produkten notwendig.
Konservierungsbelastungstest (Challenge Test)
Wir testen die Stabilität des Produkts, indem die Wirksamkeit des vorliegenden Konservierungssystems bei mikrobieller Kontamination gemäß den Vorgaben der ISO 11930 und EP 5.1.3 geprüft wird.
Sterilitätsprüfung
Zur Gewährleistung mikrobiologischer Reinheit von kosmetischen Mitteln und zum Ausschluss von Kontamination durch Mikroorganismen ist die Anwendung von Prüfmethoden gemäß des USP 71-Standards unerlässlich.
Messung der Wasseraktivität
Die Bestimmung des aW-Werts ist ein wichtiger sekundärer Faktor zur Vorhersage des mikrobiellen Wachstums und daher unerlässlich für die Bewertung von Produktsicherheit und -stabilität.
Methodenvalidierung
Die Validierung umfasst Methoden zur Neutralisierung, Verdünnung und Auswahl der Nährmedien, um für jede Produktmatrix zuverlässige Testergebnisse sicherzustellen.
Überwachung der Umgebung
Ein Hygienekonzept in der Produktion erfordert die Überwachung von Oberflächen, Luft und Wasser hinsichtlich mikrobieller Belastung, um Kreuzkontaminationen wirksam zu vermeiden.
Mikrobielle Identifizierung
Ermittlung der Kontaminationsquellen durch präzise Identifikation der Art der Organismen mittels MALDI-TOF-Massenspektrometrie und PCR-Sequenzierung.
Nachweis spezifischer Mikroorganismen
Die Prüfung auf Krankheitserreger wie E. coli, S. aureus und P. aeruginosa mittels validierter Methoden gemäß ISO-Normen und Pharmakopöen, schützt VerbraucherInnen und erfüllt regulatorische Anforderungen.
Maßgeschneiderte mikrobiologische Prüfungen
Wir entwickeln individuelle Prüfprotokolle und bieten analytische Unterstützung für spezifische Anforderungen – sei es für ein Produkt oder dessen Produktionsumfeld.
Präzise Lösungen für Ihre regulatorischen Herausforderungen
Kosmetikhersteller stehen ständig unter wachsendem regulatorischem Druck – insbesondere durch die EU-Kosmetikverordnung (EG) 1223/2009.
Der Nachweis von mikrobiologischer Qualität von der Rezeptur bis zum marktfähigen Produkt ist erforderlich, doch viele Unternehmen verfügen nicht über die nötigen Ressourcen, um komplexe und sich ständig weiterentwickelnde Standards zu kontrollieren.
Genau hier kommen wir ins Spiel.
Das Labornetzwerk von Eurofins Cosmetics & Personal Care (C&PC) bietet umfassende mikrobiologische Prüfdienstleistungen, die eine optimale Produktsicherheit und die Einhaltung gesetzlicher Vorgaben gewährleisten – mit effektiven Konservierungssystemen und minimalem Risiko einer Kontamination. Unsere akkreditierten Labore liefern zügig präzise und verlässliche Ergebnisse.

Mehrwert über die gesetzlichen Anforderungen hinaus
Mehr als nur Prüfungen:
Eurofins Cosmetics & Personal Care (C&PC) liefert Vertrauen und Tempo
Mit Eurofins C&PC haben Sie einen starken Partner für die Sicherheit Ihrer Produkte und das Einhalten regulatorischer Anforderungen an Ihrer Seite. Wir stellen Ihren Prozessen für Qualitätskontrolle und Produktentwicklung fundierte technische Expertise, breit aufgestellte regulatorische Expertise und eine globale Laborinfrastruktur zur Verfügung.
- Akkreditierte Labore:
Alle Prüfungen werden in nach ISO/IEC 17025 akkreditierten Laboren für kosmetische Produktmatrizen durchgeführt. - Unterstützung bei der Einhaltung gesetzlicher Vorgaben:
Unsere Analysen werden gemäß ISO-, EP- und USP-Standards sowie der EU-Verordnung (EG) 1223/2009 durchgeführt. - Individuelle Prüfpläne:
Maßgeschneiderte Lösungen je nach Produkttyp, Herstellungsverfahren und Risikoprofil. - Verkürzte Durchlaufzeiten:
Zügige Prüfprozesse und Berichterstattung ermöglichen eine raschere Produktentwicklung.
Ihr Partner für mikrobiologische Prüfungen
Das Labornetzwerk von Eurofins Cosmetics & Personal Care (C&PC) bietet akkreditierte mikrobiologische Tests für kosmetische Produkte. Wir prüfen Rohstoffe, Bulkware und marktfähige Produkte auf mikrobiologische Verunreinigungen, Wirksamkeit von Konservierungsmitteln und Sterilität – gemäß ISO-, EP- und USP-Spezifikationen.
Unser Service umfasst Gesamtkeimzahlbestimmungen, Pathogennachweise, Konservierungsmittelbelastungstests, Wasseraktivitätsanalysen und Umweltmonitoring. Darüber hinaus unterstützen wir mit jahrzehntelanger Branchenerfahrung bei der Methodenvalidierung sowie der Identifizierung der Keime mittels MALDI-TOF und PCR, um die Qualität Ihrer Produkte zu sichern und alle globalen Anforderungen und Standards zuverlässig zu erfüllen.
Warum Eurofins C&PC für mikrobiologische Prüfungen?
Einzigartige Erfahrung
Wir betreuen führende Marken der Körperpflege sowie Lohnhersteller in Europa, Nordamerika und Asien.
Globales Netzwerk
Zugang zu über 900 Laboren weltweit – darunter spezialisierte Zentren für kosmetische Mikrobiologie.
Maßgeschneiderte Lösungen
Ob Sie eine neue Rezeptur auf den Markt bringen oder ein Produkt im Rahmen der Marktüberwachung betreuen – wir passen uns Ihren Anforderungen an.
Präzise, Schnell, Zuverlässig
Dank effizienter Abläufe und umfassender Beratung stehen Geschwindigkeit und Qualität auf gleicher Stufe – Sie müssen sich nie zwischen einem von beiden entscheiden.





